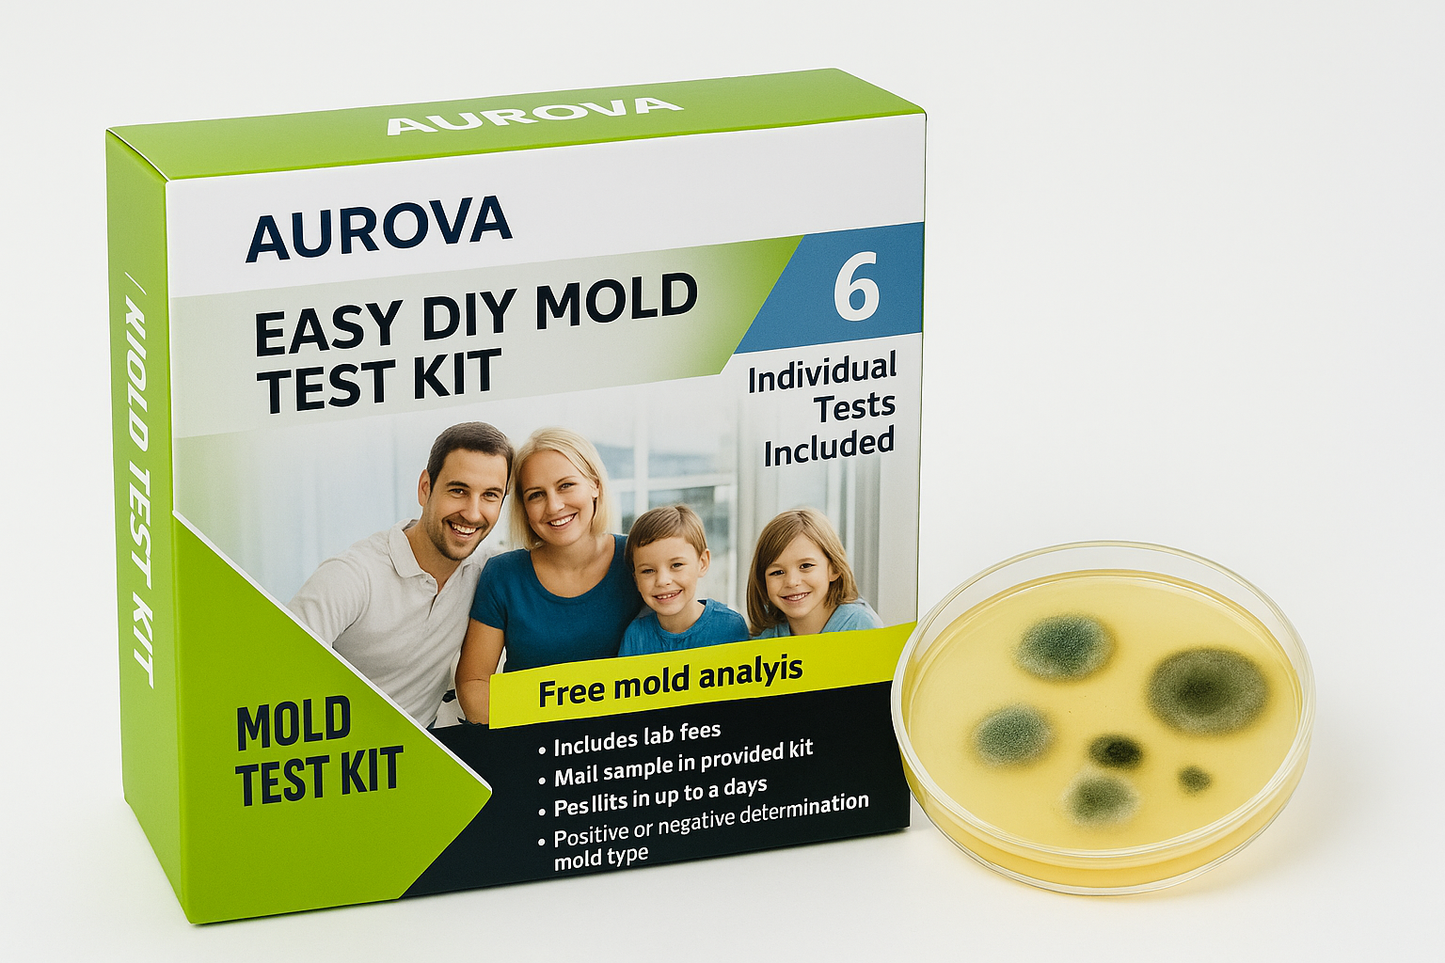
Mold Testing Kit- 6 simple mold detection tests, tests bathrooms, basements, surfaces, and more.
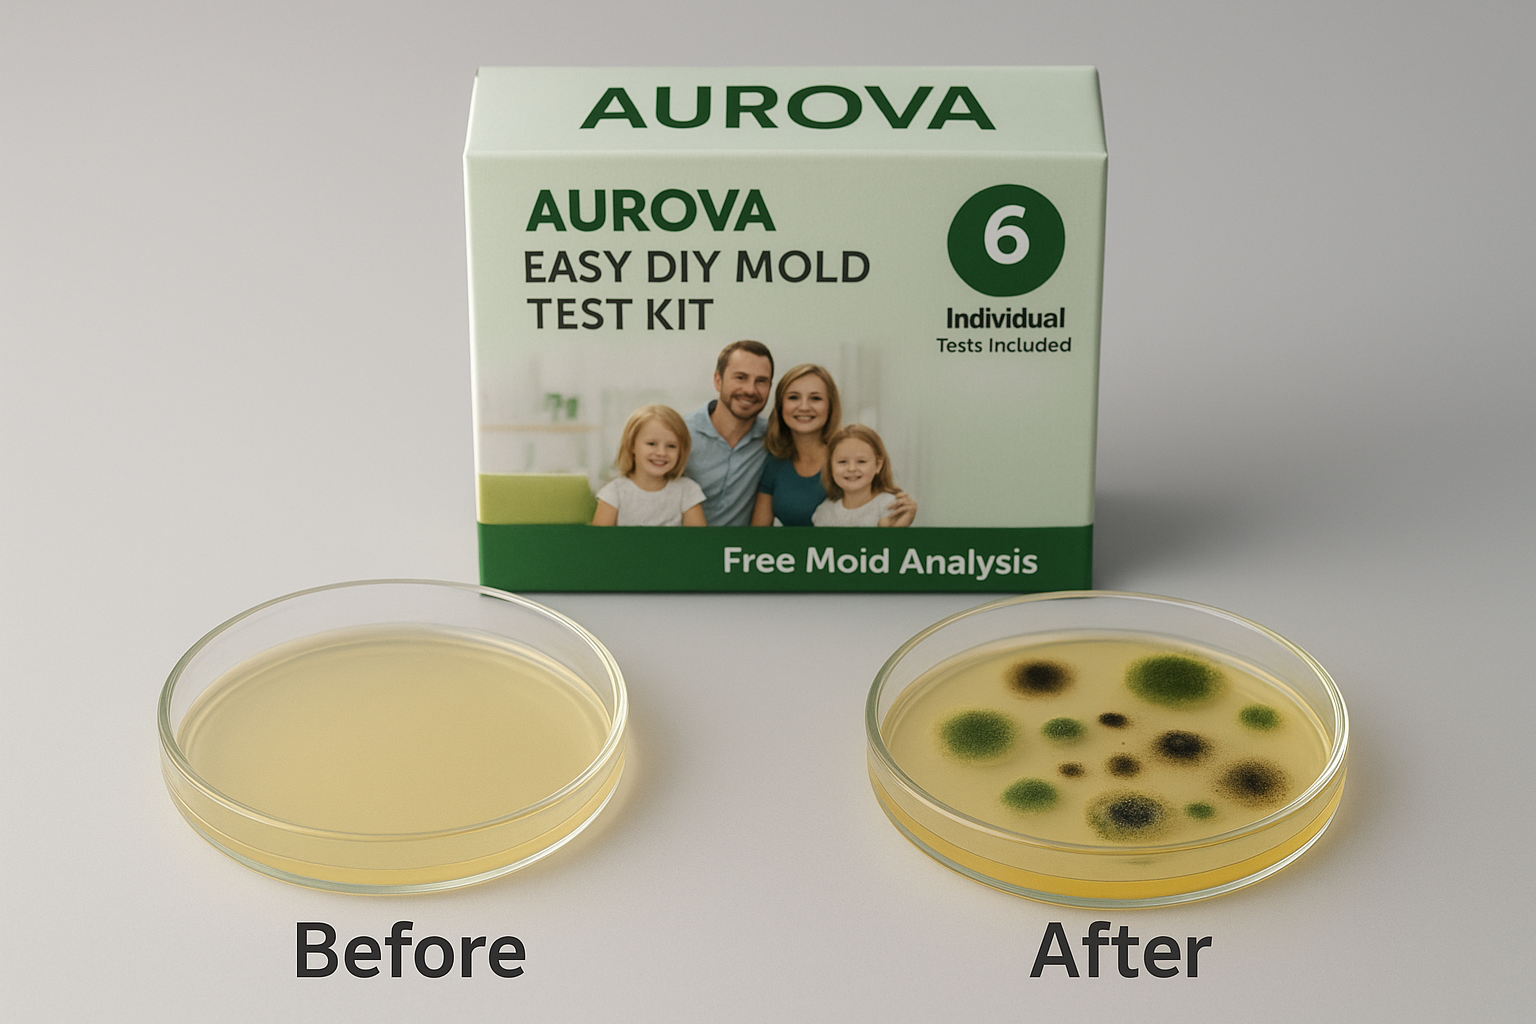
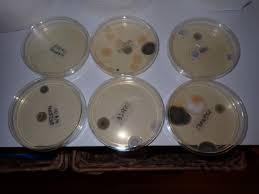
After
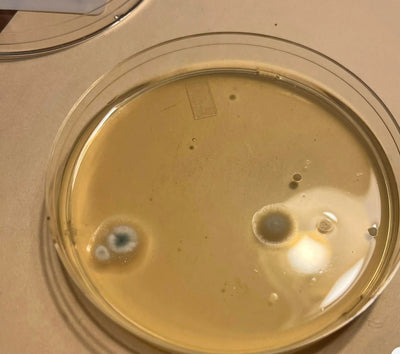
After

At Aurova, we believe peace of mind starts with the air you breathe. Our Mold Testing Kit is designed for simplicity and accuracy, giving you clear results right at home—no labs, no waiting. With Aurova, protecting your home and health has never been easier.
Easily detect hidden mold in your home or office. This all-in-one kit includes everything you need to collect samples and send them to a certified lab for analysis. Fast, accurate results. No special tools required.
1️⃣ Easy to Use – Simple sample collection with clear instructions
2️⃣ Fast Results – Get detailed lab results within days
3️⃣Test Multiple Areas – Includes supplies for multiple sample locations
4️⃣Safe & Reliable – Non-toxic, mess-free, and accurate testing